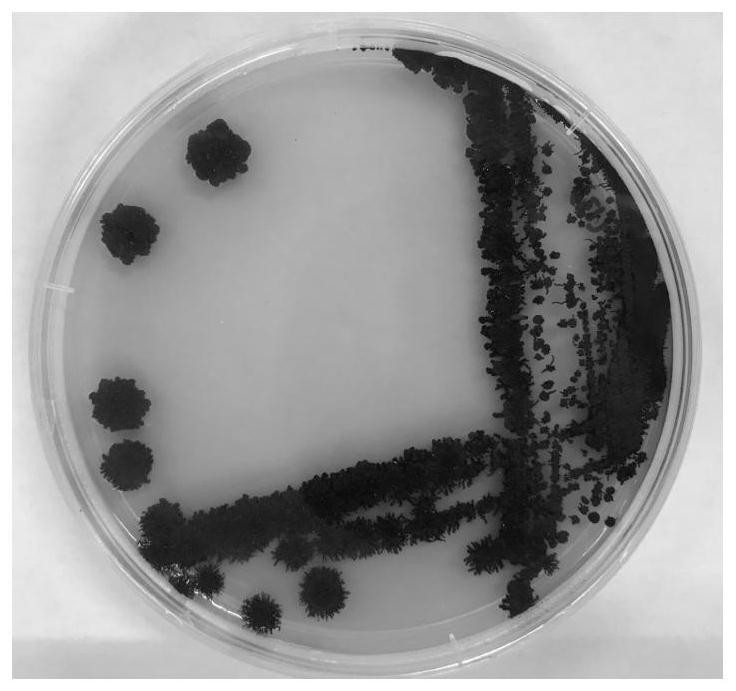
一种短梗霉菌株及其在2,5-二羟甲基呋喃合成中的应用

指梗霉属

我弟的手 只有这个大指姆上面才有 不知道是什么求告知怎么才能快速的
图片尺寸768x1024
10699622" data-lemmaid="10699622">霜霉科 /a>指梗霉属下一植物种
图片尺寸470x647
狼疮;1)全身性硬皮病;皮肤科见于(疾病晚期,逐渐出现手指背面汗毛消失
图片尺寸1080x1440
不明原因的手指坏疽
图片尺寸640x479
font color=red>霜 /font>指霉属
图片尺寸1481x1010
不明原因的手指坏疽
图片尺寸640x479
体内有病,手指先知?手指出现哪些异常要注意
图片尺寸640x360
这是什么植物啊,高分求解,去野外衣服上粘上去的,粘
图片尺寸1267x846
【供应禾指梗霉】图片
图片尺寸332x424
败血症手指长出紫蓝斑你知道是什么细菌么
图片尺寸640x570
手指拇指坏疽伴感染
图片尺寸3264x2448
belvisia mucronata (fee) copel.
图片尺寸473x710
指节垫knucklepads
图片尺寸1000x630
甘蔗指霜霉
图片尺寸180x220
一种高产β-葡聚糖的出芽短梗霉及其应用
图片尺寸444x205
microsorum zippelii (blume) ching
图片尺寸700x439
一种短梗霉菌株及其在2,5-二羟甲基呋喃合成中的应用
图片尺寸736x691
我的微观世界 梗霉,sda早期白色菌落,后期灰色或棕黑色, - 抖音
图片尺寸702x762
34谷子白发病
图片尺寸920x690
莴苣盘梗霉(bremialactucae regel) 藻菌纲 霜霉目 霜霉科
图片尺寸750x1011